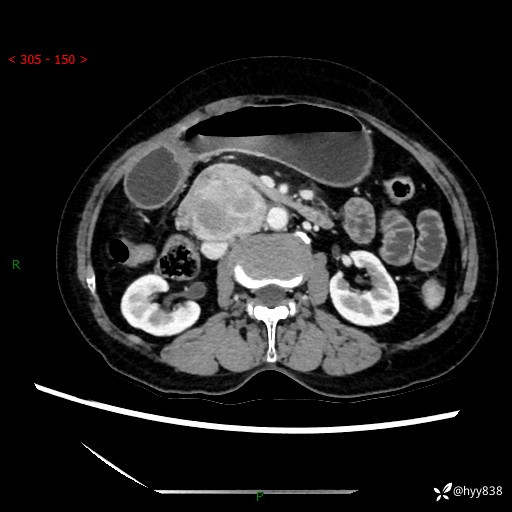
img

71岁/女,腹痛1月余。腹膜后肿物,间质瘤 VS 副节瘤 VS 平滑肌肉瘤---(有结果)
病例信息
【患者信息】:71岁/女
【主诉】:腹痛1月余
【现病史及既往史】:患者于1月前无明显诱因出现右下腹部疼痛不适,呈阵发性隐痛,尚可耐受,放射至后背部及腰部疼痛,伴排便困难,不伴其它部位疼痛,无嗳气,无不洁饮食,无黑便,无恶心、呕吐、腹胀腹泻、呕血、发热、寒颤、厌油、黄疸,多次就诊于当地区太湖医院拍片示: 行抗炎等对症支持治疗,效果尚可。现患者上述不适症状明显进一步加重,为求进一步治疗遂来我院门诊就诊,门诊以“十二指肠肿瘤?”收住我科。 起病以来,精神、睡眠可,食欲可,大便异常、小便正常,体力、体重无明显下降。
【检查】:腹部CT增强扫描(外院CT平扫)

【临床诊断】:
【治疗经过及结果】:

最后编辑于 2024-11-03 · 浏览 1591